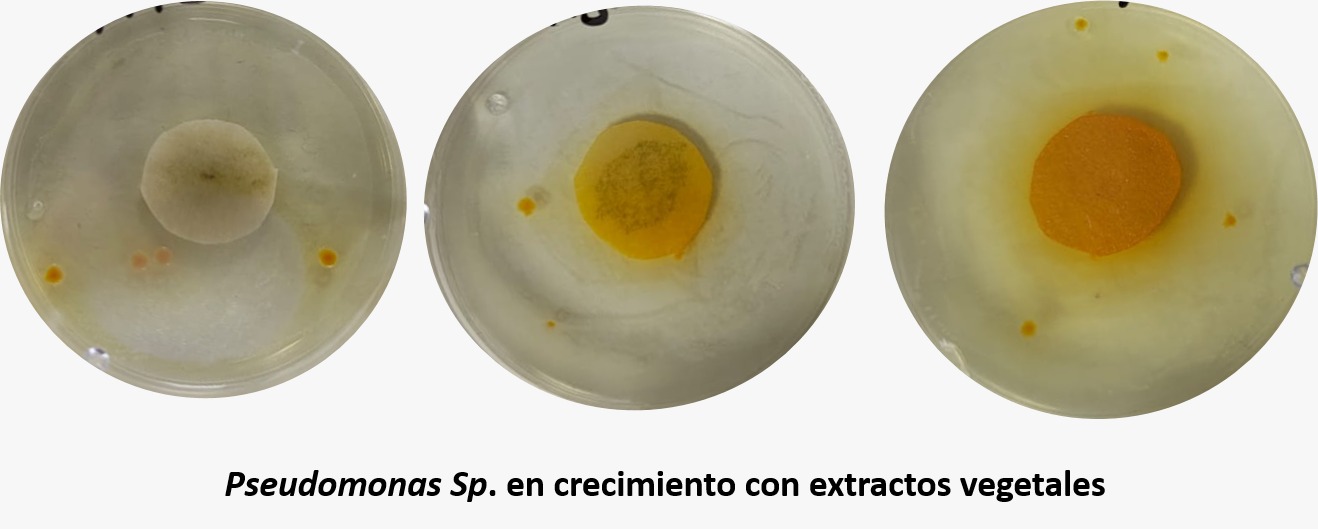
En Tlaxcala, existe un extracto para combatir la plaga de nematodos que reduce la producción de los jitomates 4 40ded295 a1a9 42c0 91a0 2be02b470aa7

- Investigadores podrían evitar la merma por nematodos en la siembra de jitomates en Tlaxcala.
Tlaxcala, Tlax.- El jitomate, uno de los principales productos agrícolas de México y líder mundial en exportación, enfrenta un riesgo considerable por la presencia de nematodos agalladores. Esta plaga puede reducir hasta en una tercera parte la producción de los invernaderos, generando pérdidas económicas que a nivel global se calculan en 190 mil millones de dólares.
En entrevista para Escenario Tlx, la investigadora Jeisel Flores y el Doctor Raúl J. Delgado, del Centro de Investigación en Biotecnología Aplicada del Instituto Politécnico Nacional (IPN), mencionaron que han dedicado más de siete años al estudio de bacterias benéficas y extractos vegetales para enfrentar este problema.
El descubrimiento de su investigación fue por un interés comercial debido a que México es uno de los 10 principales productores a nivel mundial. De acuerdo la Planeación agrícola Nacional 2027-2030, la región 12 integrada por Hidalgo, Puebla y Tlaxcala, Tlaxcala es considerado como un espacio estratégico para el mercado del jitomate. La región tiene una participación en la producción nacional de jitomate con 1.84%, lo anterior con datos de 2016.
El reto principal ha sido la detección temprana, de acuerdo con los investigadores, los nemátodos afectan a otros cultivos como las papas, la berenjena e incluso el chile. A esto, se le agrega que el principal problema para combatir este nemátodo, es que los daños que ocasiona se observan hasta 60 días después de su siembra, que es cuando la planta ya presenta agallas en las raíces, y no se puede salvar.
«Cuando empezaron a producir los jitomates se dieron cuenta que tenían pérdidas económicas hasta de una tercera parte de su producción, y eso es a nivel mundial en general». – Raúl Delgado
Los nematodos son gusanos redondos microscópicos que infestan o dañan las plantas, especialmente en la raíz, propagándose fácilmente por determinadas condiciones ambientales como el suelo, el agua, la maquinaria agrícola y el material de plantación infectado. En ese sentido, Delgado señaló que identificaron este comportamiento en la región de Chignahuapan, en donde personas agricultoras sembraron papa, y al realizar el cambio de cultivo por jitomate, crearon condiciones necesarias para que hubiera una mayor producción de nematodos.

Delgado señaló que este comportamiento es parte de la generación natural de bacterias, las cuales cumplen con cuatro funciones:
- La primera es que metabolizan los nutrientes y al metabolizarlos permiten a la planta poder absorberlos mejor y poder tener un mejor desarrollo. Es decir, un mejor crecimiento.
- La segunda es que tienen una mayor fijación de nitrógeno y eso ayuda a las plantas a poder crecer de mejor manera.
- La tercera es que al generar ese ambiente, las mismas plantas empiezan a tener un mayor tolerancia a los estreses por temperatura como calor o frío y también contra plagas.
- Y la última, genera una mayor cantidad de biomasa y esa cantidad genera mayor producción.
Ante este panorama natural, el nematodo se habita y contamina los cultivos. Por lo que el equipo científico creó un sistema de espectroscopía infrarroja que permite identificar la presencia de nematodos en los primeros 15 días de cultivo, lo que brinda a los agricultores la oportunidad de tomar decisiones rápidas y reducir costos en agroquímicos.

Sin embargo, este equipo llega a costar hasta 2 millones de pesos en laboratorio y 600 mil con una versión semiportátil. Por lo que la investigadora, Jeisel Delgado está desarrollando una formulación a base de extractos vegetales que al no contar con un tiempo de vida útil, se coloca en la superficie de la siembra y se conserva de manera perenne, lo que genera que las bacterias suban a la superficie y se encuentren con este extracto teniendo un 100% de mortalidad para el nematodo.
Estas investigaciones se han aplicado en invernaderos de Tlaxco, con resultados positivos en la disminución de infestaciones. No obstante, los científicos señalan que las prácticas agrícolas, como la falta de rotación adecuada o el reúso inmediato de suelos sin tratamiento, continúan favoreciendo la propagación de la plaga.

Las primeras 2 raíces contienen módulos y las dos de abajo son raíces después del tratamiento con extractos de nematodos.
Además, la combinación de bacterias benéficas y extractos vegetales representa una alternativa sustentable frente al uso de nematicidas químicos, los cuales suelen ser poco efectivos a largo plazo y dañan la fertilidad del suelo.
“Si los productores pueden detectar el problema en los primeros días evitan pérdidas, reducen el uso de químicos y logran un cultivo más sano”, señaló Delgado.
El trabajo busca consolidarse como una estrategia integral para proteger al jitomate y otros cultivos afectados —como papa, chile y berenjena— frente a esta amenaza persistente.